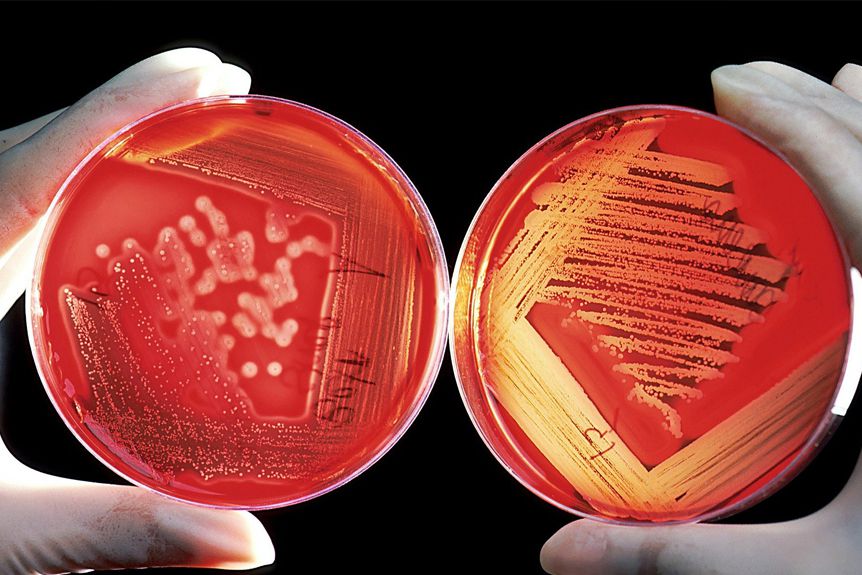

MRSA-Zucht beim Hund
In den vergangenen Wochen riefen mich mehrere Patientenbesitzer an, um meine Meinung einzuholen. Der Sachverhalt war immer ähnlich.
Hund absolut frei von Symptomen oder Verdauungsauffälligkeiten soll bis zu 12 (!) Tage ein Antibiotikum einnehmen, weil bei einem vorsorglichen Parasitencheck (auf Würmer/Wurmeier) mittels einer Sammelkot-Probe ein Giardienbefall festgestellt wurde.
12 Tage Antibiotikum für einen symptomfreien Hund? Ernsthaft?
Wir wissen mittlerweile, dass ein akuter Giardienbefall mittels eines Schnelltestes festzustellen ist – nicht mit Sammelkot. Wir wissen auch, dass über 70% aller Hunde diesen Einzellern ein Zuhause geben – diese aber nur behandelt werden sollten, wenn sie Probleme machen, wie z.B. stinkenden, schleimigen Durchfall. Mensch & Tier sind voll von Parasiten, Keimen, Erregern, wahrscheinlich auch infektiösen Giardien-Zysten und sogar entarteten Zellen – das ist normal!! Deshalb sollen wir ja unser Immunsystem und die Zellen unseres Körpers stärken und nicht ständig herausfordern. Die Pflege eines gesunden Mikrobioms im Darm mit Kräutern, EMS und guten Bakterienstämmen ist dabei überaus wichtig für den gesamten Organismus.
Wir können beobachten, dass herkömmliche chemische Keulen bei massivem Giardienbefall kaum noch wirken und wir daher auf natürliche Alternativen wie z.B. Enterogan/Usniotica von PerNaturam oder Giardex-Kräuterpillen zurückgreifen sollten. Diese Kräuterpräparate können auch mal vorbeugend kurweise gegeben werden, um mögliche Giardien-Zysten zu binden und auszuleiten.
Wenn wir unseren gesunden Hunden 12 Tage ein Antibiotikum verabreichen, brauchen wir uns nicht zu wundern, wenn sie Resistenzen entwickeln und im Notfall keines mehr wirkt. Eine Infektion mit MRSA (Methicillin-resistenter Staphylococcus aureus) ist nicht nur kostspielig für die Hundebesitzer – für die Hunde selbst bedeutet eine MRSA-Infektion oftmals einen langen Leidensweg, der z.B. bei Infektionen in den Gelenken auch mit großen Schmerzen verbunden ist.
Auf der anderen Seite werden manchmal Zahnsanierungen durchgeführt, bei denen extrem starker, dunkelbraun-grauer Zahnstein entfernt wird – ohne ein Antibiotikum zu verabreichen, obwohl es für die Behandlung der massiven Entzündungsherde im Maul und aufgrund der Freisetzung großer Mengen an Bakterien m.E. sinnvoll wäre. Hier solltet ihr auf jeden Fall Alternativen wie koll. Silber, Propolis, Anokath Liquid oder andere hochwirksame, antibakteriell wirksame Mittel einsetzen!
Ein Antibiotikum ist ein wichtiges Notfallmittel, das -bewusst verabreicht- Leben retten kann! Es sollte nicht bei jeder Lappalie und schon gar nicht ohne vorheriges Antibiogramm eingesetzt werden. Im Anschluss an eine Antibiotika-Gabe macht es Sinn, das Darmmilieu aufzufrischen - der Darm ist die Wurzel des Lebens, hier sitzt das Immunsystem und hier entstehen Allergien und diverse Erkrankungen.
Gastbeitrag unserer ehemaligen Schülerin Susanne Orru-Benterbusch.
{fastsocialshare}